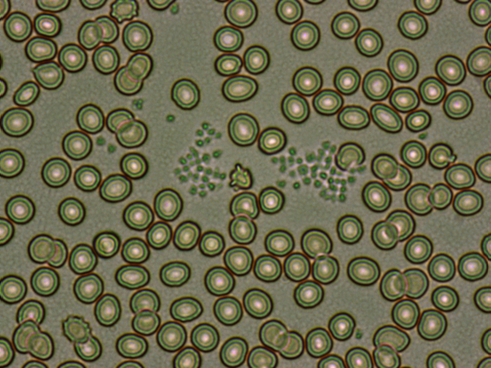

临床更换药物,PLT由聚集转为不聚集?真相是……
EDTA-K2依赖性PLT减少症在工作中偶尔会遇到,其机制虽尚不明确,目前主流观点是免疫因素介导,如EDTA可导致血小板活化,因而改变血小板膜表面某种隐匿性抗原构象,与存在于血浆中的自身抗体结合。
近期,科室在发现一例ICU患者首诊出现EDTA-K2依赖性PLT减少症,经过几天的追踪,临床更换抗生素药物后,PLT由聚集转为不聚集?实际情况到底如何,现介绍如下。

10月7日上午临检班,在审核到50号标本时,发现血小板减少?PLT 86×109/L,PLT报警信息:PLT Clupms?(血小板聚集?),如图1、2。

图1

图2
由于10月6日同事交接班时,说到过此患者有PLT聚集现象。于是推片,进行干片浏览,确实发现PLT聚集,如图3、4。
图3

图4
刘氏染色后,镜下如图5、6,血小板聚集现象一目了然。

图5

图6
对于EDTA-K2诱导的PLT假性降低,目前科里采取的纠正措施有:1、枸橼酸钠抗凝管进行血常规测试,PLT总数乘以1.1后再发出结果。 2、患者于检验科窗口采血,立即上机测试(不给抗凝剂诱导PLT聚集的时间)或立即涂片、染色、镜检,用PLT估算公式进行估算。
自己在进行PLT校正后,以PLT 122×109/L结果发出。事情进展到这,是不是感觉已经完结了?还没有,比较神奇的一幕来了。
10月10日早上,晚班同事交班说到:该患者昨晚的血常规测试竟然没有PLT聚集报警,且PLT总数为152×109/L,竟然回归正常了?
调取患者10月9日18:49晚上结果,如图7、8,确实没有PLT报警信息。

图7

图8
这顿时引起了自己的好奇,PLT由聚集转为不聚集?难道患者体内免疫因素的抗体没有介导?
更让自己好奇的是,发现患者10月9日上午有血常规结果,PLT 97×109/L,报警信息:PLT Clupms?(血小板聚集?),如图9、10

图9

图10
一天的时间内,上午出现了PLT聚集报警,晚上就神奇的没有报警信息,且PLT总数还回归正常?
电联临床,咨询临床在10月9日是否进行了一些诊疗方案的调整?比如,做手术、输血、换药等?
临床表示,患者依旧如之前的治疗,只是更换了一种抗生素,由头孢唑林钠换成了哌拉西林钠他唑巴坦钠。临床10月6日使用头孢唑林钠,如图11。于10月9日10:49使用哌拉西林钠他唑巴坦钠。

图11

图12
在向临床请教了两者药物区别,得知:哌拉西林药物为半合成的青霉素,与头孢唑林相比较,哌拉西林的抗菌谱更广,且副作用也更小。
疑问重生
1、根据时间进行推算:10月9日上午11:18血常规PLT 97×109/L(报警PLT聚集),临床10:49使用哌拉西林药物,晚上18:49血常规 PLT 152×109/L(无PLT报警信息)。
莫非是因为使用了哌拉西林药物导致PLT由聚集转为不聚集?在检验学术听课中,自己只听过老师讲解的使用阿米卡星可以解聚PLT。但阿米卡星是体外的测试,采集完血液后定量加入的药物。
2、到目前为止,暂时还未看到报道:患者自身因素的由PLT聚集转为不聚集,可能原因是免疫因素介导的抗原抗体反应,一般比较难消除。
既然疑问不断的冒出,真实的情况到底如何,患者10月9日晚上的血常规到底有没有聚集,推片镜检不就可以一切真相大白了吗?
将晚班同事已涂好的片子进行染色,镜检发现:患者的血涂片依旧存在PLT聚集现象,只是PLT聚集的程度并没有像之前一样那么的多、那么严重,较为多见的是比较分散的一小簇聚集,这也就可以解释,10月9日晚上血球仪没有报警PLT聚集。如图13,还可见到一个中性粒细胞假性P-H畸形,考虑药物因素所致。

图13
对于10月9日晚上没有PLT聚集报警的血常规,其PLT 152×109/L也并不是真实的PLT总数,如果再加上镜下稍微大簇聚集的PLT,其真实PLT结果应更高一些(说明PLT-I阻抗法计数血小板的弊端)。

(1)综合整个案例来看,一直围绕着患者的PLT进行纠正,主要是因为免疫因素介导的PLT聚集(或者说是EDTA-K2诱导的PLT聚集)比较难消除,这种EDTA依赖的现象或许会伴随患者还更长时间。
(2)尽管临床在更换了抗生素药物后,血球仪未见PLT报警,PLT总数也回归了正常,但显微镜下仍然可见小簇的PLT聚集。说明此次临床医生在进行药物的更换、使用,对于EDTA-K2诱导的PLT减少症的改善,其影响并不是非常明显。(注:体外实验的阿米卡星除外)
(3)查询电子病历得知,患者于10月6日因“活动后气紧4月,加重伴呼吸困难8小时”入院,由于较多基础病和并发症、病程较重,收入ICU诊治。10月10日早上患者由ICU病房转入内科病房。
检验科在患者入院后血常规中一直查出仪器报警PLT聚集,直到10月9日晚上没有PLT报警。说明患者的病情情况在逐渐好转,体内的免疫因素干扰趋于降低,最后EDTA-K2诱导的能力也下降,PLT计数开始回归正常。PLT作为疾病的一个监察官,对疾病的预后也有一定的提示作用,特别是PLT总数的开始上升,也正好和患者的临床症状好转相对应。
(4)当然,在以后的时间内,如果患者的病程加重,免疫因素开始主导,其诱导PLT聚集的能力又会被恢复,这需要我们继续追踪患者的情况。

综上所述,临床更换了抗生素药物,PLT由聚集转为不聚集,仅仅只是仪器认为的不聚集,真实的情况需要我们结合显微镜镜检进行确认,镜下所见的仍然有小簇聚集,说明了免疫因素介导的干扰只能被降低,而不能被彻底消除。在这其中,患者的病情好转将会起到比较重要的作用。

